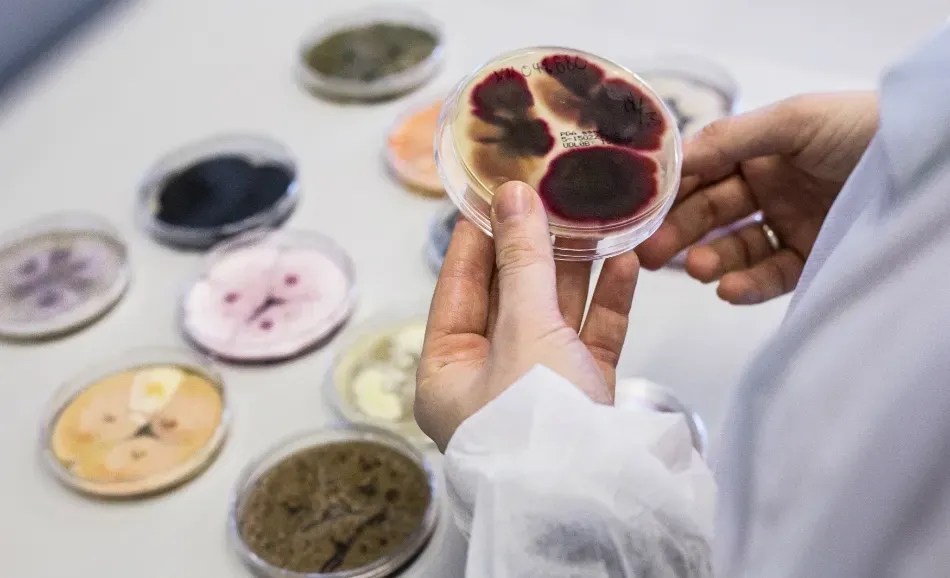

Microorganisms are everywhere. Forty million in a single gram of soil. One hundred trillion in the gut flora of the average human. Among this soup of single-celled, microscopic organisms are microbes such as bacteria, which, among other things, produce enzymes.
Enter Novozymes. Headquartered in Bagsværd, just outside Copenhagen, this Danish biotech firm has been putting enzymes to commercial use for the last 70-plus years.
The precise science is complex, but the essence of Novozymes’ business is straightforward. Think of enzymes as nature’s change agents. When one substance turns into another — yeast into bread, say, or milk into cheese — enzymes are helping that transition happen.
Novozymes’ strength is in helping adapt this catalytic process to specific industrial applications. Today, its enzyme-based products and solutions are used in over 40 industry sectors, from household care and bioenergy to agriculture and animal health.
For the most part, the company uses fungi (Aspergillus oryzae, mostly) to produce the enzymes that it needs, drawing on the work of its 1,000-plus large team of researchers around the globe.
But what does this all have to do with sustainability? Quite a lot, it transpires. For one, enzymes are biodegradable. Second, unlike raw materials, they don’t form part of a final substance: they are catalysts, not components. Put together, that’s less waste and less resource use.
As important, enzymes work at low temperature and at moderate pH levels. That means you can wash your clothes at a lower-than-usual heat and an enzyme-based washing liquid will deliver the same results if not better.
Enzyme-based solutions also open the possibility of using fewer chemical inputs. Consider leather. When untreated, leather is super stiff. Sulphide, a toxic component, is usually used to help soften the protein components that stiffen leather — a function that enzymes can assist with (reducing sulphide use by 40 percent in the process).
The potential of enzymes to slash energy consumption and reduce chemical use endows these biologically active proteins with something akin to sustainability superpowers.
Novozymes’ leadership is committed to use these powers for good. And not just the good of shareholders. On the first page of its Articles of Association, the company commits to operate in a “sustainable” manner; namely, with “environmental and social regard,” as well as the normal financial perspicuity you would expect.
Cutting direct emissions through collaboration

How to achieve this balance relates in part to how the company manages the impacts of its own operations. Even with the best will in the world, creating enzymes in three-story fermentation tanks is an energy-intensive business.
But through a combination of energy efficiency measures and investments in renewables (the firm’s Denmark operations have relied 100 percent on wind energy since 2011), Novozymes’ overall carbon dioxide (CO2) intensity has dropped by 11 percent since 2014 — surpassing its target 2017 of 9 percent.
Over recent decades, Novozymes has won particular acclaim for its pursuit of a circular production system at its Kalundborg site on Zealand, Denmark’s largest island. In conjunction with eight other private and public sector organisations, the “Kalundborg Symbiosis” has developed a range of innovative solutions to facilitate cooperation in the use of water, steam, energy and other resources.
Most recently, the consortium saw the energy provider Ørsted (formerly DONG Energy) inaugurate the largest biogas plant in eastern Denmark. The plant, which uses biomass residues from Novozymes’ local facility to generate power, promises to slash annual carbon emissions by an estimated 17,000 metric tons.
In addition, Novozymes and several of its partners are helping to keep the air clean in Kalundborg. As part of a 20-year purchase agreement with Ørsted, energy supply to Novozymes no longer will come from coal but instead from wood chips. The new facility, due to open in 2019, is set to reduce CO2 emissions by around 800,000 metric tons (35,000 of which are attributable to Novozymes).
For Justin Perrettson, the company’s head of global engagement in the Sustainability team, such examples demonstrate the “very rigorous process” that Novozymes has for reducing its own environmental impact. As he noted: “You can always challenge yourself to do more, but I think Novozymes is quite tough on itself and I think that’s fair.”
Catalysing consumers’ carbon reductions
Internal environmental improvements (and emission reductions, in particular) are only part of the picture. The real prize, he insisted, is using the company’s cutting-edge enzyme technologies to reduce emissions outside Novozymes’ four walls.
“The main way that Novozymes has approached the reduction of climate emissions is through the use of its products and services by its customers,” said Perrettson.
To that end, the company has set itself the exacting goal of saving 100 million metric tons of CO2 emissions per year through the application of its products, by 2020. Last year’s count saw it hit 76 million (the equivalent of taking 32 million cars off the road).
Contributing a significant chunk of these reductions are Novozymes’ laundry products, which, as mentioned, enable consumers to reduce energy consumption by washing at lower temperatures. Another major contributor is the company’s fuel ethanol solutions, which see it swap the use of fossil fuels for bio-based feedstocks.
Two principles characterize Novozymes’ long-standing efforts to reduce consumer emissions. The first is scientific exactitude. The Danish biotech isn’t one to come out with rough “guestimates.”If it says it’s reducing 76 million metric tons of CO2 every year, you can bet the math is there to prove it.
“Our approach to the whole sustainability and climate change discussion is rooted in science. It is super important to us to show that there is a scientific validation for everything that we claim.” So says Jesper Kløverpris, a senior sustainability specialist in the company’s three-person team responsible for life cycle assessments (LCAs). Novozymes has been carrying out LCAs to determine the environmental profile of its products and solutions since 2004.
Such a rich bank of data gives the company an almost unprecedented picture of its overall carbon footprint. It also enables the company to accurately calculate potential emission savings should its current markets expand or new solutions emerge.
A case in point is the work of Kløverpris and his colleagues around corn-based animal feed in the United States. Based on four separate LCAs, the The One Acre Study report interrogates the environmental benefits of Novozymes’ biosolutions in the agricultural value chain.
The results make compelling reading. Consider the product JumpStart. Sold as part of a seed inoculant, the product contains a naturally occurring soil-organism called Penicillium bilaiae (P.b.). P.b. improves the ability of crops to take up nutrients, which leads to higher yields. The subsequent surplus can, in the case of corn at least, be used to produce starch-based ethanol.
Or take Ronozyme HiPhos, an enzyme-based product that increases the digestibility of animal feed as well as reducing the need for (carbon-intensive) inorganic phosphorus. A variant on the product — the amylase Ronozyme HiStarch — helps reduce the fat going into chicken feed. As with extra crop yields, this saved fat can be used for biodiesel production (aided by the enzyme product Novozymes Eversa, which converts glycerides and free fatty acids).
The potential impact of this suite of products is striking. The LCA team calculate that a single acre of cropland could provide 13 U.S. gallons of biodiesel, 32 pounds of protein-rich animal feed and 230 kWh of clean electricity. That’s all alongside producing feed for 900 chickens, as before.
“If you calculate for the resource savings and the bioenergy production (among other things), that leaves you with a total reduction in greenhouse gas emissions of 1.1 metric ton of CO2 equivalents per acre,” Kløverpris stated.
Scale that up to every cornfield in the United States and then the numbers become properly staggering. Ten billion extra U.S. gallons of bioethanol, for instance; 21 TWh of bioelectricity; 120 million pounds of pure phosphorus saved. The result? A total saving of almost 90 million metric tons of greenhouse gases.
Of course, those numbers suppose mass adoption of Novozymes’ products. Despite year-on-year growth, the company isn’t there yet. Which leads to the other main pillar of its emission reduction strategy: innovation.
At present, the Danish biotech leader ploughs around 13 percent of its annual revenues back into research and development. Its pipeline of new research projects runs to over 100.
But it’s not just product innovation where the company invests its creative energies. Bringing its nous and know-how to the design of novel business models and breakthrough policies also forms part of the mix.
One area of ongoing focus, for instance, is in the biorefinery market. The transport and energy sectors desperately need electrification (renewable electrification, that is). On that score, Novozymes is categorical. It also sees a huge role for sustainable biofuels as the transport and energy sectors transition away from fossil fuels over the coming decades.

“Even with some of the most aggressive scenarios, it won’t be until 2045 or 2050 that we get a break even between purely electric passenger cars and cars running with combustion engines,” said Kløverpris. “Plus, it’s hard to electrify certain forms of transport, such as heavy-duty vehicles, planes and shipping. So we need an alternative to liquid fossil fuels and that alternative is low-carbon biofuels.”
Meanwhile, integrated biorefineries have the ability to produce more than low-carbon liquid fuels. Co-products such as biogas and solid combustibles can be stored and used for electricity production during peak demand periods when other renewables such as wind and solar cannot meet the full demand. Besides, the highly concentrated stream of biogenic CO2 from fermentation processes can be captured and stored to generate negative greenhouse gas emissions, a measure that will be “badly needed” to meet international climate targets, according to Kløverpris.
The company therefore has developed a series of innovative blueprints for how the biorefinery market could be scaled up. Its plans incorporate the adoption of new technologies, novel commercial opportunities and progressive public policies.
“We have presented our vision at several bioenergy conferences already, and we are also working with experts in academia to challenge our thinking,” said Kløverpris, adding that the company’s strategy has “lots of resonance” with the bioenergy “roadmap (PDF)” recently published by the International Energy Agency.
Actioning the company’s vision for biorefining won’t happen overnight, he admitted. That said, it need not take years either. He points to the example of Brazil, where the government recently introduced a new national biofuels policy.
A similar commitment to large-scale, collaborative change is behind its decision to link up with the World Business Council for Sustainable Development. Novozymes is channeling its energies and expertise into two of the business network’s main clean energy programs: the Low-Carbon Technology Partnership initiative and the below50 initiative (which focuses specifically on the development of sustainable fuels).
Dual benefits
Novozymes’ combination of science and innovation is already delivering major benefits for climate change. Seventy-six million metric tons of CO2 averted is no mean feat.
According to Ridhima Kapur, a senior analyst in Novozymes’ sustainability team, clear benefits also exist for the company itself. Not only does the firm’s environmental performance inspire its 6,000-plus employees (nicknamed internally as “Zymers”), but it’s also attracting favorable interest from institutional investors.
The positive emissions’ profile of Novozymes’ products are winning it an edge in the marketplace as well. In industries such as bioenergy, the case for low-carbon solutions is quite clear, Kapur admitted. But even in consumer-facing industries, such as home care, Novozymes’ eco-credentials are winning it new business.
She cited the example of Nice Group, one of China’s largest detergent manufacturers. Spurred on by a new green manufacturing program from the government, the company approached Novozymes to help it understand the environmental impact of its products and identify areas of improvement.
“They came to us and asked if we could help with an initial LCA of a specific product,” she said. “We’ve been talking about sustainability for years. But to have a company come to us and ask for this, and to say it wants to make greener products and change consumer demand, is terrific. It’s basically why we do what we do.”

That lone red sock soon may no longer be a threat to your white laundry thanks to a mushroom enzyme that neutralizes dyes. Aside from the payoff to launders, molecular biologists say the method behind this mushroom madness, described in the current issue of Nature Biotechnology, is the first to combine two gene mutation techniques with shuffling and sorting procedures to improve an enzyme’s function. Experts say the approach, called directed evolution, may someday become a staple of the chemical industry.
Several companies are working on directed evolution of enzymes–they mutate the enzyme’s gene, then sort out the ones that show the most improvement. To evaluate their own approach to directed evolution, Joel Cherry and his colleagues at Novo Nordisk Biotech in Davis, California, decided to develop an enzyme to chew up dyes that leach out of colored clothes in the wash. Peroxidases can do this but can’t stand the heat, alkalinity, or hydrogen peroxide concentrations in a washing machine.
Starting with a peroxidase from the inky cap mushroom, which is easy to grow in large quantities, Cherry’s group first studied the enzyme’s crystal structure and amino acid sequence, then deliberately mutated stretches of amino acids they thought would be susceptible to peroxide attack or vulnerable to heat destruction. Separately, they introduced random mutations into the gene by copying it with a faulty polymerase chain reaction.
After sorting out the mutants with the highest activity under washing machine conditions, they put a mixture of the 10 most promising ones into yeast cells. With a natural propensity to recombine similar genes, the yeast created thousands of different mutant combinations. After selecting the best, the researchers introduced more random mutations, then shuffled and sorted again. The resulting peroxidase was 174 times more stable in hot water and 100 times more resistant to hydrogen peroxide attack than the original enzyme. And to boot, it prevented dyes from running from a red cloth to a white one. “It’s really effective,” Cherry says.
The study proves that deliberate and random mutations can be screened for a commercial product, says Jeremy Minshull, a molecular biologist at Maxygen Inc. in Redwood City, California. “It has very strong implications for the chemical industry,” he says. “It allows you to combine multiple properties in the same enzyme.” For instance, he says, one enzyme that can perform under many conditions might replace a bunch of enzymes that function in a narrower environment.

Final Spin
From the soil beneath our feet to the enzymes in our laundry detergent, Novozymes proves that tiny organisms can have enormous impact. By harnessing the power of fungi and molecular biology, the company is not only revolutionizing the way we wash our clothes but also cutting emissions, saving energy, and creating sustainable solutions across agriculture, bioenergy, and beyond. Who knew a microscopic protein could be such a superhero for the planet—and your laundry?
Support My Work
If you enjoyed this deep dive into the world of enzymes and sustainable innovation, support The Laundry Club Blog so we can keep exploring the fascinating science, history, and hidden stories behind the clothes you wear and wash.
Leave a comment